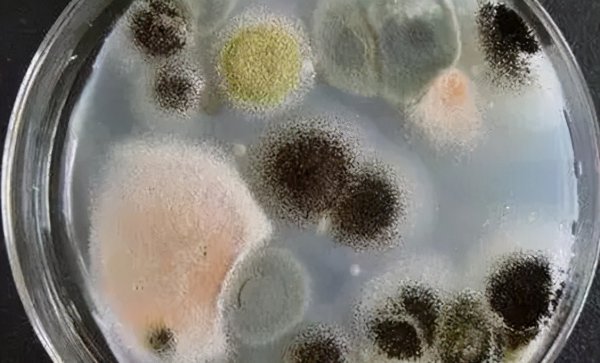
有机菌肥长白毛是好肥吗

有机菌肥长白毛是好肥吗 微生物菌肥长毛效果好不好
对于许多女生来说有机菌肥长白毛是好肥吗方面的经验,具体详情如下:

微生物菌剂是一个比较特殊的肥料,它不含养分,但是却能够促进根系发育,提升养分的吸收效率,尤其是对土壤调节能起到良好的作用。
因此其使用率也越来越高,也催生了很多关于微生物菌剂的“谣言”,好菌肥会长毛就是其中之一。
微生物菌剂都出毛?
当你打开一袋微生物菌剂,发现里面的肥料都出毛了,会作何感想?
有的销售人员声称,微生物菌剂都会长毛,而且只有长毛的微生物菌剂,才是真正的微生物菌剂,你会相信吗?或许不少人会被这样的话语所欺骗,然而实际情况并非这样。
首先,微生物菌类当中确实会有容易长毛的,比如木霉菌、哈茨木霉菌等真菌,都比较容易长毛,只有在比较严格的情况下才会不长毛。
但是,我们日常所使用的微生物菌剂当中,几乎是以芽孢杆菌为主的,它不属于真菌类,因此是不会长毛的。
所以说,当微生物菌肥长毛时,肯定是肥料出现了问题。有可能是产品没有发酵彻底,也可能是储存环境不当,总之出毛的微生物菌剂是一定不能用的!

含菌量越高越好?
我们都知道微生物菌剂当中的成分是有益菌,它们能够活化土壤中的养分、改善土壤中菌类的构成,从而促进根系的发育和成长、减少土传病害的发生。
所以说,微生物菌剂当中的含菌量能够从一方面代表其功效,但是如果刻意来强调自身含菌量的话,就要注意了。
正常情况下菌肥的菌丝都是白色、灰白色、浅黄色或者透明色,我们如果看到菌肥是绿色、灰黑色、黑色的菌丝。
毫无疑问,这是杂菌甚至是有害菌,使用这种菌肥不仅无益于作物生长,甚至可能带来危害。
而我们在说含菌量的时候,谈的是“有效含菌量”,而不是无论什么菌类都算在其中,很多产品标榜着5亿、10亿的含菌量,乍一看好像很有实力,其实并非如此。
要知道,我们随便摘取一片树叶,叶片上可能都含有上万的菌类。
对于微生物菌剂,国家标准是:微生物菌剂产品颗粒的是≥1亿,液体是≥2亿,生物有机肥是≥0.2亿,如果产品含菌量大幅超过这个指标,那么就是有问题的。
微生物菌肥见效很慢
根据肥料的见效速度,我们通常把肥料分为速效性肥料和迟效性肥料,其中我们比较常见的水溶肥、复合肥、叶面肥等都属于速效性肥料,见效比较快。
而微生物菌剂、有机肥、微生物菌肥等都属于迟效性肥料,这些肥料见效慢,但是肥力持续时间比较持久。
微生物菌肥见效虽然慢,但是如果长期无效就有问题了,而且现在一般制成菌剂的都是活性比较高的微生物菌种。
它们在土壤中能很快产生效果,快速形成优势菌落进行作用,效果也并不慢,并且安全环保。
所以说,微生物菌剂效果慢并不是绝对的,它相对水溶肥、叶面肥来说是相对慢一些,但是也基本能在一周内见到效果。
相关阅读
-
莲花和荷花是同一种花吗 莲花和荷花是两种不同的花卉
『常识社』网为你介绍莲花和荷花是同一种花吗的生活小知识,具体内容如下: 莲花和荷花为什么不同,有区别吗? 莲花和荷花是两种不同的花卉,它们在外貌和特征上有明显的区别。 在中
-
蓝莓怎么留种子 种子繁殖时间与方法
对于大多数女性来说蓝莓怎么留种子方面的经验,一起跟随小编看看具体内容吧! 蓝莓留种子方法 蓝莓又叫做笃斯、黑豆树、都柿等,它的种子长在球型的果实之中,花后的70-90天后就会有种
-
对红是否怕冻 对红冬天怎么养护
冬天养对红需要及时的采取保暖措施,最好是将其搬到室内进行养护,还可以放在室内有阳光照射的地方,保证有适量的光照,利于过冬。另外,对红冬季养护还要注意合理浇水,因为冬天是
-
大葱的软腐病要怎样防治 大葱软腐病症状病因及防治方法
本文分享的大葱的软腐病要怎样防治 大葱软腐病症状病因及防治方法的全部内容,您了解了吗? 大葱软腐病的症状表现 大葱软腐病属于细菌性病害,大多发生在大葱生育中后期,主要危害大


